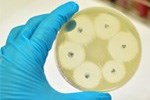

Veterinary Epidemiology, Economics & Public Health - Projects
Training Injury Prevention Study
The overarching aim of this project is to inform intervention strategies to reduce the risk of musculoskeletal injury in Thoroughbred racehorses in training.
WAVES: Working towards Adaptive and Versatile Environmental Sustainability in Mollusc Aquaculture
UK Research and Innovation (UKRI) has granted funding to the Royal Veterinary College (RVC) as part of a crucial project researching the sustainability of mollusc aquaculture in southeast Asia.
Predicting injury risk and post-injury outcomes in Jump racehorses in Great Britain
This project aims to identify risk factors for injuries and predict post-injury outcomes. Outputs will inform race-day injury prevention and rehabilitation and improve injured horses’ likelihood of returning to racing.
Sustainable and Healthy Food Systems - Southern Africa (SHEFS-SA)
SHEFS-SA is a transdisciplinary, multi-institutional project funded by the Wellcome Trust and led by the University of KwaZulu-Natal in South Africa. Its overall aim is to catalyse the transformation of Southern African food systems and communities (specifically in South Africa, Malawi, and Zimbabwe), towards ones that are healthy and resilient to climate change risks. The RVC’s role focuses on livestock source food systems.
Health of domesticated cattle in rewilding
Domesticated cattle are used in rewilding projects to utilise their ecological impacts upon these systems. Human expectations, and therefore health measures, of these animals differ from those of farmed livestock.
FluTrailMap (Poultry) consortium
The project brings together leading researchers at top UK scientific organisations to better understand and mitigate the threats of bird flu viruses to the poultry sector.
Critical Research on Industrial Livestock Systems (CRILS) Network
The Critical Research on Industrial Livestock Systems (CRILS) Network aims to understand the trade-offs of large-scale, industrial livestock systems and to use available evidence to advocate for just and sustainable food systems, especially in the Global South. The network brings together researchers and non-academics including civil society, activists, policy-makers, industry actors, and lawyers among others, to challenge and nuance narratives of livestock production systems.
Improved Stewardship to Protect Veterinary Antimicrobial Usage in UK Cats and Dogs
This study aims to identify and promote effective antimicrobial stewardship interventions in UK first-opinion companion animal practice. Our objectives are to benchmark current antimicrobial usage in dogs and cats, develop and implement a range of antimicrobial stewardship interventions, evaluate the impact of these interventions, and promote widespread adoption of the most effective interventions across the UK.
The epidemiology and genetics of congenital musculoskeletal disorders in neonatal Thoroughbreds
The project aims to investigate the contributions of gestational exposures and genetic variants to the risk of congenital developmental orthopaedic disorders (cDOD) in Thoroughbred foals.
The project will provide novel insights into the development, incidence and genetic basis of cDOD in Thoroughbred foals. The project outputs will inform evidence-based management modifications for Thoroughbred breeders to reduce the risk of cDOD in foals and improve broodmare fertility and welfare long-term.
Retraining and rehoming former UK racehorses
The racing industry is committed to the health and welfare of all horses bred for racing, throughout their lifetime. However, there is a need to better understand what happens to racehorses when they leave racing or training, and what makes them suitable for a successful career in other equestrian sports disciplines, as leisure horses or companions. The overarching aims of this project are to provide a comprehensive overview of the landscape of former racehorse rehoming and to better understand what factors influence a former racehorse’s suitability for a second career and/or successful rehome.
‘Nursing Matters’ – an investigation of mental health in the veterinary nursing profession
RVC researchers are conducting a much-needed investigation of mental health and wellbeing amongst RVNs and SVNs, aiming to identify issues that can be changed to provide better support.
Early-life determinants of performance and the Economics of Thoroughbred breeding
The project aims to improve understanding of the impact of Thoroughbreds’ early-life health and management on later-life racing performance and the financial viability of Thoroughbred breeding enterprises.
Findings from the project will align with key priorities from the Thoroughbred industry’s welfare strategy. Firstly, by increasing transparency around the fate and welfare of Thoroughbreds bred for racing during their early-life stages, and secondly by informing strategies to reduce musculoskeletal disease and injury and improve industry retention and economic viability.
Genomic epidemiological determination of routes of pathogenic virus transmission between farmed salmon
Viruses in farmed salmon harm the UK's economy, decrease industry sustainability, and reduce fish welfare. Piscine myocarditis virus (PMCV) and infectious salmon anaemia virus (ISAV) are particularly damaging. This project aims to improve understanding of how these viruses spread between farms, and hence inform actions that can improve disease control and reduce disease incidence.
A Framing Analysis of Media Reactions to The UK's National Food Strategy
Led by Dr Mehroosh Tak, Senior Lecturer in Agribusiness at the RVC, this policy research project aims to analyse the reactions and uptake of the National Food Strategy (NFS) recommendations through a framing analysis of media and press coverage since its release in July 2021.
Equine Safety and Welfare in British Horseracing
The racing industry is committed to improving the welfare and safety of racehorses.
Better understanding of risk factors for injury and fatality can inform evidence-based strategies to reduce their occurrence.
Do lop-eared rabbits have more dental and aural disease than erect-eared rabbits?
Initial evidence has shown that rabbits with artificially selected extreme morphological traits of lop ears and brachycephaly experience reduced welfare through a higher prevalence of painful ear and teeth problems, a cause for concern as lops and dwarves are the most popular pet rabbit breeds in the UK. This study aims to determine the prevalence of these diseases in UK pet rabbits using VetCompass data that represents approximately 30% of UK practices.
VetCompass eClinical Trials (VETs) – Generating Interventional Evidence from Observational Data
The study aims to develop innovative statistical approaches to veterinary electronic patient records to evaluate the effectiveness of clinical interventions in dogs.
This project aims to develop and apply novel causal inference methods that evaluate real world interventions via routinely collected veterinary EPRs. These methods will be applied to VetCompass data to provide real world inference for some key interventions.
Evaluation of the implementation of the UK Antimicrobial Resistance National Action Plan in the context of the COVID-19 pandemic.
The project aims to evaluate the implementation of the UK Antimicrobial Resistance (AMR) National Action Plan (NAP) 2019-2024 to contribute to the development and implementation of future AMR policy and adjustment of current implementation plans.
AMR is a global threat; microorganisms with resistance genes can spread through the movement of people, animals, food, soil, air, and water. In addition, some resistance genes can be directly transferred between microorganisms.
Contacts and Clusters: Modelling and mitigating infectious disease risks in UK competition and leisure horses
The aim of this project is to improve our understanding of equine infectious disease risks associated with the contact networks and spatio-temporal risk clusters created by competition and leisure horse movements within the UK.
Understanding these networks and clusters will inform future disease surveillance programmes and outbreak responses.
Identifying Economic and Financial Drivers of Industrial Livestock Production - the Case of the Global Chicken Industry
The project investigates asymmetries of power relations and policy formulations that give rise to corporate concentration in livestock industries using the case study of poultry. Corporate contract farming or industrialised integrated production are becoming dominant forms of meeting such demands. This guidance memo aims to investigate asymmetries of power relations and policy formulations that give rise to corporate concentration in livestock industries using the case study of poultry.
Improving animal health surveillance through better engagement between farmers, vets and government
The current research into animal health surveillance has been predominantly focused on improving the technical aspects and there is little work looking at the engagement of stakeholders with the surveillance system. UK scanning surveillance relies on the submission of samples or reports from private veterinary surgeons, which in turn rely on the propensity of farmers to seek veterinary advice. Farmers and veterinary practitioners are therefore at the forefront of disease surveillance and the data being received is shaped by what they perceive to be a threat.
Genetic and non-genetic factors in Campylobacter levels in poultry
Researchers explored variation at specific positions in chickens’ genome and their association with Campylobacter in the birds’ guts. Campylobacteriosis exerts profound societal and economic costs to the UK and other countries. The World Health Organization has estimated that Campylobacter causes 95 million illnesses, 21,000 deaths and loss of 2.1 million disability-adjusted life years globally. In the UK alone, there were 63,946 laboratory-confirmed human cases in 2017.
The study concluded that, although there are genetic factors that influence Campylobacter colonisation, these factors play a relatively minor role.
Earlier Onset Urinary Incontinence in the Bitch and its Association with Neutering
Funded by BSAVA PetSavers, this project aims to evaluate major risk factors for development of urinary incontinence in bitches. In particular, it will explore the association between neutering and age at time of neutering with onset of early incontinence.
The project will provide relevant and reliable evidence that can support a more universal approach from veterinary surgeons and provide advice to dog owners regarding neutering.
Utilising the ‘Surveillance of Equine Strangles (SES)’ outputs to better understand the dynamics and control of Streptococcus equi transmission
This project aims to better understand the dynamics and control of Streptococcus equi transmission and optimise the effectiveness of veterinary advice to, and adoption by, horse owners for preventing and controlling strangles.
The Surveillance of Equine Strangles (SES) network was launched in 2018 to capture and report epidemiological and genomic data relating to laboratory diagnoses of strangles in the United Kingdom.
CoEval-AMR: Convergence in Evaluation Frameworks for Integrated surveillance of Antimicrobial use (AMU) and Antimicrobial Resistance (AMR)
The CoEval-AMR network was created in 2019 with the goal of bringing people together to harmonize and refine existing methods and tools for assessing AMU and AMR surveillance from an integrated and systemic perspective.
Multiple research groups worldwide are working on the evaluation of integrated AMU/AMR surveillance looking at how approaches and methods can be refined to provide information that is relevant for making decisions on what surveillance approaches to use and thereby support the management of AMU and AMR. So far, the work of different research and implementation groups has resulted in multiple frameworks and disjointed recommendations for evaluation and measurement, which can be confusing for users.
UKRI GCRF Action Against Stunting Hub
The UKRI GCRF Action Against Stunting Hub is conducting vital research to address the intractable global challenge of child stunting. We work directly with communities across India, Indonesia and Senegal who are facing this burden. Applying a holistic, Whole Child Approach, we’re developing child-focused interventions to prevent, improve and even reverse some key features of this global issue. The tools and approaches we develop in the Hub have the potential to change the lives of a million children worldwide.
UK Research and Innovation (UKRI) Global Challenges Research Fund (GCRF) One Health Poultry Hub
With integrated streams of social, economic, biological, mathematical and policy-led research, we are co-producing detailed knowledge on the biological, structural and socio-economic factors that shape networks of chicken production and distribution. The RVC-led UKRI GCRF One Health Poultry Hub brings together leading laboratory, clinical, veterinary and social scientists, as well as skilled communications experts, programme support staff and external stakeholders.
Sustainable Beef & Sheep Food Systems
This project brings together different disciplinary and One Health specialists from two collaborating universities; the Royal Veterinary College and the University of Hertfordshire to contribute creatively to solutions for more sustainable beef and sheep production and marketing systems in Great Britain.
Using trans-disciplinary, systems modelling approach we aim to map the British beef and sheep food systems and identify metrics of sustainability for each farming system to create an integrated model to assess impacts.
Hot Dogs - investigating the epidemiology and recognition of heat-related illness in dogs presenting to UK veterinary practices.
This project began by exploring risk factors for heat-related illness in UK dogs and has been extended to develop and evaluate a novel clinical grading tool that aims to improve recognition and management of this potentially fatal condition.
Understanding the risk factors for heat-related illness is an important step in developing improved mitigation strategies to help protect canine welfare in the face of advancing climate change.
Canine leptospirosis: improving diagnostics and understanding epidemiology in UK dogs
This project aims to explore the epidemiology of canine leptospirosis in the UK by identifying spatial patterns of disease, diagnosis risk factors and incidence of disease. Alongside this work is being undertaken to explore vaccine usage and vaccine adverse events. Additionally, a novel serological assay with potentialp DIVA ability is being explored.
Understanding drivers, incentives and economic impact of foot-and-mouth disease control in Kenya
This project is studying the economic and social factors that influence how foot-and-mouth disease is controlled in Kenya at local and national levels. Understanding the socioeconomic drivers that affect disease control within relevant livestock systems, and the cost-effectiveness of control options are important components of designing FMD control programmes.
Molecular analysis of the prevalence of antibiotic resistance among Enterobacteriaceae in food-producing animals and humans in Southeast Nigeria
A study of extended-spectrum β-lactamases (ESBL)-producing bacteria in food-producing animals and in-contact humans in Southeast Nigeria.
The indiscriminate use of antimicrobial agents in humans and livestock imposes a selective pressure for the emergence of antimicrobial resistance among bacteria. In Nigeria, the production of extended-spectrum β-lactamases (ESBL) has been recognised as a common mechanism of resistance to third-generation cephalosporins among Enterobacteriaceae.
Foodborne diseases and public health governance: Comparing food safety, consumer preferences and governance in the supply of meat to urban markets.
Foodborne diseases are a major cause of morbidity, mortality and undernutrition including micronutrient deficiencies, with animal-derived food posing the highest risk for consumers in low and middle-income countries such as Peru. Traditional food markets are still the dominant distribution channel for locally produced food in developing countries and the main food source for most poor urban households. The research explores the safety of meat supplied through traditional food markets that serve poor urban consumers.
The Sustainable and Healthy Food Systems (SHEFS) programme
SHEFS is led by the London School of Hygiene and Tropical Medicine, and the RVC’s work will focus on livestock-derived foods (LDF) in South Africa.South Africa bears a triple burden of malnutrition, with persistent levels of stunting, micronutrient deficiencies and rising obesity. LDF provide an energy dense and micronutrient rich food, important for pregnant and breast-feeding women and children’s cognitive development. However, they may also present health risks through overconsumption, foodborne diseases and chemical hazards and have a greater environmental impact than plant-based diets.
AMFORA: Applying a One Health systems approach to formulate strategies for mitigating risk to human health of AMR in Aquaculture
The aim of AMFORA is to use a ‘systems-thinking’ approach to map aquaculture systems and identify hotspots for the emergence and selection of resistance and human exposure to antimicrobials and antimicrobial-resistant organisms.
This will enable the identification of potential drivers of AMU and interventions to reduce AMU.
Antibiotic usage on dairy farms in GB: improving data capture and exploring drivers
The aims of this PhD were to determine the accuracy of antibiotic usage data being recorded by dairy farmers on farm, identify factors influencing accurate recording, assess the drivers and barriers to record and share such data and to explore the economic cost of recording. Antibiotic usage (ABU) has become recognised as the main driver for the selection and spread of antibiotic resistance (ABR) within the human and livestock sectors.
Evaluating the surveillance system for Antimicrobial Use (AMU) and Antimicrobial Resistance (AMR) in the United Kingdom from a One Health perspective
The project aims to assess the value of integrated surveillance systems for AMU and AMR in the UK from a One Health (OH) perspective.
Antimicrobial resistance (AMR) is a global health threat with major economic implications. Bacteria carrying resistance genes can be transmitted between humans, animals and the environment. Therefore, an integrated surveillance programme for AMR and antimicrobial use (AMU) needs to take into consideration the various routes of AMR transmission.
Control of brucellosis in dairy herds in Rwanda
We are working with overseas partners to research the frequency and distribution of brucellosis among dairy herds, and longitudinal studies to identify Brucella species causing infection in dairy herds.
Brucellosis is the world's most widespread zoonosis, imposing a substantial burden on the livelihoods of poor people as a result of human disease and reduced livestock productivity. However, brucellosis is rarely a priority for health systems and for this reason the WHO classifies brucellosis as a "neglected endemic zoonosis"
The Network for the Evaluation of One Health (NEOH) / the Network for Ecohealth and One Health (NEOH)
The Network for Evaluation of One Health (NEOH) was an international EU-COST (European Cooperation in Science and Technology) funded network (2014-2018) that aimed to enable evaluation of One Health activities and comparison of initiatives, as well as informed decision-making and resource allocation. It was then converted into the Network for Ecohealth and One Health as the European Chapter of Ecohealth International that has several active working groups.
Peste des Petits Ruminants (PPR) Programme
The Peste des Petits Ruminants programme involves partners in Europe, Asia and Africa working collaboratively to generate evidence to support global PPR eradication. In 2015, FAO and OIE developed a global strategy that aims to eradicate PPR by 2030. This strategy heavily relies on large-scale vaccination of sheep and goats, vaccination monitoring and disease surveillance.
SERVAL (SuRveillance EVALuation framework)
A generic framework for the evaluation of animal health surveillance. SERVAL is based on a conceptual model that can be applied to any surveillance system. A set of 22 system attributes are defined and guidelines to their qualitative and/or quantitative assessment are provided.
Animal health surveillance programmes are necessary to obtain quality evidence to inform the management of threats to animal and public health. This investment yields benefits for animal owners and for industries including food and leisure that depend upon a healthy animal population.
Saiga Mass Mortality: ongoing research on causes of mortality in saiga antelope in Kazakhstan and Mongolia
The saiga project is a long-term contribution from RVC to research into understanding of the causes of mortality of the saiga antelope. This species ranges in the Steppes of Asia, in a few localities but is classified as critically endangered by the International Union for Conservation of Nature red listing process. The study findings to date provided unique information on the cause of mass mortality of saiga and the impact of PPR on saiga antelope.
Epidemiology of Tuberculosis in Cattle
We study the epidemiology of tuberculosis in cattle using a combination of fieldwork and the analysis of big data. Bovine tuberculosis (bTB) is caused by infection with Mycobacterium bovis. It is the most pressing animal health problem in Great Britain. Around 40,000 cattle test bTB-positive each year and are slaughtered in an effort to control this disease. This comes at a cost to the taxpayer of around £100 million per year in surveillance testing and compensation.
Field approaches to identifying tuberculosis in badger populations
We study the epidemiology of tuberculosis in wild badgers using a combination of fieldwork, laboratory investigations and long-term data analysis.
Tuberculosis (TB) occurs worldwide and affects many animals (farmed and wild) as well as humans. In cattle, TB is caused by infection with the bacterium Mycobacterium bovis and is sometimes referred to as bovine TB.
Interactions between species: Implications for disease transmission
A study of the contact patterns between a wide range of species to better understand the risks of disease transmission between livestock, wildlife and people. Many diseases spread between species. Humans are no exception: we share most of our infectious diseases with other hosts. This means we may become infected from other species (for example, catching rabies through being bitten by an infected dog) or we may be the source of infection to other species (for example, spreading antibiotic-resistant bacteria to livestock or pets).
VetCompass Project
VetCompass is a welfare-focussed epidemiological research project that shares anonymised clinical data from veterinary practices to investigate the frequency and nature of companion animal health problems.
Modern veterinary medicine has access to increasingly effective tools for diagnosis and treatment; yet many animals still continue to suffer from disorders that might be reduced or avoided if risks were better understood and measured.
Responding to the challenge of MERS-CoV: Development and testing of interventions to reduce risk among Bedouin populations in southern Jordan
Middle Eastern Respiratory Syndrome coronavirus (MERS-CoV) is an emerging infectious disease first identified in Jordan and Saudi Arabia in 2012. Clinical cases present as an acute respiratory infection with rapid onset pneumonia and, in many cases, death.
In this interdisciplinary research, we study the biological and sociocultural contexts of the disease among at-risk Bedouin populations in southern Jordan. In particular, we are seeking to understand which individuals, or camels, should be targeted for future vaccination, the correct seasons for the deployment of such vaccines and the sociocultural issues that are driving the infection.
Epidemiology of Tuberculosis in Meerkats of the Kalahari
Research project by the Royal Veterinary College investigating the epidemiology of Tuberculosis in meerkats in the Kalahari Desert in southern Africa.
Meerkats (Suricata suricatta) are social mammals that live in groups. A potential disadvantage of being social is that infectious diseases are more likely to spread. Tuberculosis (TB: a bacterial infection) was first detected in wild meerkats in southern Africa in the late 1990s.